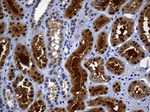
ASL Antibody in Immunohistochemistry (Paraffin) (IHC (P))

Search
OriGene
ASL Monoclonal Antibody (OTI9G2), TrueMAB™
{{$productOrderCtrl.translations['antibody.pdp.commerceCard.promotion.promotions']}}
{{$productOrderCtrl.translations['antibody.pdp.commerceCard.promotion.viewpromo']}}
{{$productOrderCtrl.translations['antibody.pdp.commerceCard.promotion.promocode']}}: {{promo.promoCode}} {{promo.promoTitle}} {{promo.promoDescription}}. {{$productOrderCtrl.translations['antibody.pdp.commerceCard.promotion.learnmore']}}
产品信息
TA804902
种属反应
宿主/亚型
分类
类型
克隆号
抗原
偶联物
形式
浓度
规格
纯化类型
保存液
内含物
保存条件
运输条件
靶标信息
ASL encodes a member of the lyase 1 family. The encoded protein forms a cytosolic homotetramer and primarily catalyzes the reversible hydrolytic cleavage of argininosuccinate into arginine and fumarate, an essential step in the liver in detoxifying ammonia via the urea cycle. Mutations in this gene result in the autosomal recessive disorder argininosuccinic aciduria, or argininosuccinic acid lyase deficiency. A nontranscribed pseudogene is also located on the long arm of chromosome 22. Alternatively spliced transcript variants encoding different isoforms have been described.
仅用于科研。不用于诊断过程。未经明确授权不得转售。
篇参考文献 (0)
生物信息学
蛋白别名: argininosuccinase; Argininosuccinate lyase; argininosuccinate lyase (EC 4.3.2.1); Arginosuccinase; ASAL; unnamed protein product
基因别名: ASAL; ASL
UniProt ID: (Human) P04424
Entrez Gene ID: (Human) 435